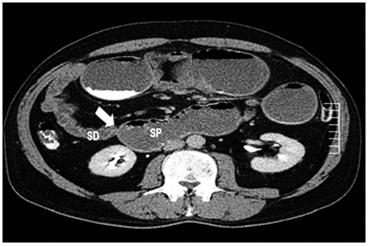

Introducción
Los tumores de intestino delgado son inusuales. A nivel global, representan de 0,3 a 2 % de los cánceres gastrointestinales; en Estados Unidos, representan el 0,4 % de los cánceres gastrointestinales, y el 0,2 % de las muertes asociadas con malignidad 1. En Panamá, para el 2012, por tener una incidencia reportada tan baja, se califican dentro del grupo “resto de causas de malignidad” que, en general, representa solamente el 0,1 % 2.
Aunque su causa se desconoce, se observa una mayor incidencia después de los 60 años, en raza negra, en hombres y, en algunas ocasiones, se ha asociado con la clase social alta, sin embargo, aún no hay evidencia que lo confirme 3.
Es un cáncer con muchos subtipos histológicos y poco frecuente, probablemente, por tener varios factores de protección que evitarían llegar a la neoplasia; sin embargo, se cuenta con muy pocos estudios que puedan explicar su baja incidencia 3.
El adenocarcinoma es el tipo más frecuente, 30 a 50 % de los casos, seguido del tumor del estroma gastrointestinal (GIST), el tumor carcinoide, el linfoma y el leiomiosarcoma. La mitad de los casos se observa en el duodeno y el 25 % se encuentra en el yeyuno 4,5.
El adenocarcinoma de yeyuno, al producir síntomas inespecíficos, requiere una importante sospecha diagnóstica; los más frecuentes son dolor abdominal de tipo cólico, pérdida de peso, anorexia y, en casos complicados, hemorragia y obstrucción intestinal. La tomografía computadorizada (TC), la radiografía con contraste, las endoscopias, la TC multicorte con enteroscopia virtual, la video-cápsula intestinal y la enteroscopia con doble balón, son muy útiles para su diagnóstico 6.
El cáncer de intestino delgado es poco común, no se sabe mucho de sus factores de riesgo, y su presentación clínica es vaga e inespecífica. Generalmente, se diagnostica tarde y, a menudo, requiere intervención quirúrgica. Hay una fuerte asociación entre el estadio tumoral en el momento del diagnóstico y la tasa de supervivencia, por lo cual un diagnóstico temprano es fundamental.
Caso clínico
Se trata de un hombre de 58 años, sin antecedentes relevantes, que consultó por presentar un cuadro clínico de dos meses de evolución, consistente en dolor abdominal generalizado, cólico intermitente, pérdida de peso de 23 kg, aproximadamente, en dos meses, y llenura posprandial que solo mejoraba cuando se inducía el vómito.
Por esta sintomatología, se le practicó una TC abdómino-pélvica con contraste una semana antes en otra institución, en la cual se informó dilatación de la cámara gástrica, duodeno y yeyuno proximal, con cambio de calibre abrupto a ese nivel, sin evidencia de otros hallazgos (figuras 1 y 2).

Fuente: Servicio de Radiología, Centro Médico del Caribe, Panamá
Figura 1. TC Abdomino pélvico en fase con contraste, corte axial a nivel de estómago y duodeno: dilatación de la cámara gástrica y del yeyuno.
Flecha: estrechez en el yeyuno proximal
SP: segmento proximal a la lesión
SD: segmento distal a la lesión
Figura 2. TC Abdomino pélvico en fase de contraste, corte axial.
Fue atendido en el servicio de urgencias, donde refirió que en los dos últimos días había sufrido aumento del dolor abdominal generalizado, de tipo cólico y continuo, acompañado de leve distensión abdominal y vómitos de contenido alimentario.
En el examen físico, se encontró deshidratado, con estabilidad hemodinámica, abdomen distendido principalmente en el epigastrio, ruidos hidroaéreos disminuidos, dolor a la palpación y timpanismo con predominio en el epigastrio, sin detección de masas ni visceromegalias.
En los exámenes de laboratorio de ingreso se encontró leucocitosis (14 x 103/mm3) y neutrofilia (75 %), con alteración de la creatinina (1,7 mg/dl) y del nitrógeno ureico (25 mg/dl).
Se practicó una laparotomía urgente, en la que se encontró una lesión anular de 3 cm de longitud, aproximadamente, localizada en el yeyuno proximal, a 60 cm del ángulo de Treitz (figuras 3 y 4). Se resecó a 10 cm del margen, se hizo una anastomosis latero-lateral, isoperistáltica, y se cerró el defecto con engrapadora mecánica de 3,5 mm. No se evidenció ascitis, carcinomatosis, implantes a órganos, metástasis hepáticas, ni lesiones en el tubo digestivo.

SP: segmento proximal dilatado
SD: segmento distal colapsado (flecha)
Figura 3. Lesión transoperatoria

SP: segmento proximal
SD: segmento distal (flecha)
Fuente: Servicio de Cirugía General, Hospital Irma Lourdes Tzanetato
Figura 4. Corte longitudinal de la lesión
El paciente evolucionó satisfactoriamente, con deambulación temprana en la tarde de ese mismo día; recibió dieta líquida a las 48 horas posoperatorias, se progresó en la dieta con buena tolerancia y al tercer día se le dio el egreso. No se presentaron complicaciones.
Según el estudio de histopatología de la pieza quirúrgica, se trataba de un adenocarcinoma de yeyuno, moderadamente diferenciado y polipoide, que invadía hasta la subserosa, y además, había invasión linfática y perineural. Los márgenes quirúrgicos y los ganglios linfáticos fueron negativos para tumor. Se clasificó como T3N0M0 (figuras 5, 6, 7).

Flechas: proliferación neoplásica glandular que afecta mucosa y submucosa, y atraviesa la pared muscular propia hasta la subserosa.
Fuente: Servicio de Patología, Hospital Irma Lourdes Tzanetato.
Figura 5. Proliferación glandular desordenada con glándulas de tamaños variables; epitelio atípico, caracterizado por pérdida de la polaridad, pleomorfismo nuclear, nucleomegalia y mitosis abundante. Hematoxilina eosina, 100X.

Flecha: trombos tumorales linfáticos
Figura 6. Patrón infiltrante con formación de figuras (back to back), cribas y ausencia de estroma fibrovascular entre las glándulas neoplásicas. Hematoxilina y eosina, 100X.

Fuente: Servicio de Patología, Hospital Irma Lourdes Tzanetato.
Figura 7. Infiltración perineural. Hematoxilina y eosina, 100X.
A los seis meses de seguimiento, el paciente demostró una buena evolución, y se encontró estable y asintomático.
Revisión del tema y discusión
La incidencia global del cáncer de intestino delgado es muy baja, menos de 1 por 100.000 habitantes, por lo que su estudio, comprensión y diagnóstico preoperatorio son muy limitados 3.
El cáncer de intestino delgado puede ser primario o deberse a metástasis. Los tumores primarios más comunes son el adenocarcinoma, los tumores del estroma gastrointestinal, el carcinoide y el linfoma, mientras que el melanoma es la causa más frecuente de metástasis 7,8.
El cáncer de intestino delgado más frecuente, el adenocarcinoma, se ubica principalmente en el duodeno y en el yeyuno proximal, mientras que los otros tipos se localizan más distalmente. Ocasiona signos y síntomas inespecíficos, por lo que muchas veces su diagnóstico es tardío, en un estadio avanzado de la enfermedad 9.
Su poca frecuencia se ha tratado de explicar con algunas hipótesis, como su gran longitud, el gran volumen de líquido que disminuye la irritación, el corto tiempo de contacto con los carcinógenos, y la producción de IgA y enzimas microsómicas que pueden proteger de los carcinógenos 10,11. Existen diversos factores de riesgo que pueden influir en su aparición; sin embargo, por su excepcional frecuencia y carencia de informes escritos, no se ha descubierto una causa específica. Se han considerado como factores de riesgo relacionados: las noxas ambientales, el tabaquismo, el alcoholismo y el consumo excesivo de azúcar refinada, carnes rojas o ahumadas, mientras que el café, el pescado, la fruta y los vegetales podrían ser factores de bajo riesgo 10.
Se desconoce la fisiopatología exacta de los tumores de intestino delgado, pero en algunos estudios se propone la secuencia de adenoma a carcinoma, en la cual un epitelio normal hace transición a adenoma y carcinoma por medio de eventos moleculares. Se ha observado una mutación en el gen APC, que produce una mala regulación de la β-catenina, la cual se acumula en el núcleo celular, lo que es un detonante para la enfermedad. En algunos casos se ha informado: reducción de la expresión de la caderina epitelial (E-caderina); sobreexpresión de p53; pérdida de expresión del gen SMAD4; mutación del gen K-RAS; inactivación de las proteínas de reparación del ADN (MisMatch Repair, MMR) e, incluso, expresión del gen HER2.
Así, la poliposis adenomatosa familiar (mutación del gen APC), el síndrome de Lynch (mutación de genes implicados en la MMR) y otras enfermedades inflamatorias, como la enfermedad de Crohn y la enfermedad celiaca, podrían ser causa de cáncer de intestino delgado 10.
Por lo general, la enfermedad es asintomática al iniciarse, sin embargo, en estadios más avanzados, hasta el 90 % de los pacientes presenta sintomatología y el 35 a 40 % podría tener metástasis 12. Suele aparecer entre los 60 y los 70 años de edad, aunque en casos de enfermedad de Crohn su aparición puede ser precoz 13.
Aunque el tumor produce dolor abdominal inespecífico, con mayor frecuencia es de localización baja, hay anemia cuando existen lesiones ulceradas y, por su característico crecimiento anular, llega a producir obstrucción intestinal con dolor posprandial e, incluso, perforación en casos complicados 13,14. Solo el 25 % de los pacientes podría tener una masa palpable y hasta el 25 % podría cursar con manifestaciones clínicas de obstrucción abdominal, por lo que usualmente el examen físico puede no revelar datos importantes. En casos avanzados, podría haber ictericia, ascitis, hepatomegalia y caquexia 15.
Para hacer un diagnóstico diferencial, hay muchos aspectos que se deben tener en cuenta en la evaluación y muchas entidades que se deben sospechar en casos de tumores del intestino delgado.
La causa benigna más frecuente es el adenoma y, también, se debe sospechar fibroma, hemangioma, leiomioma, lipoma, hamartoma o tumores desmoides. Cuando la histología indica una neoplasia maligna, además del adenocarcinoma, hay que considerar linfomas no Hodgkin, sarcomas, carcinomas de células escamosas, tumores neuroendocrinos o carcinoides y tumores del estroma gastrointestinal (GIST) 16,17.
Entre los tumores primarios, se deben tener en cuenta el melanoma y el cáncer de pulmón, de mama, de estómago y de colon, que dan metástasis al intestino delgado 13.
Su diagnóstico es tardío; se considera que puede transcurrir un intervalo de hasta 6 o 7 meses, desde sus síntomas iniciales hasta el diagnóstico 18. De 20 a 50 % de los casos sintomáticos se diagnostican antes de la cirugía 19.
Existen diferentes estudios que pueden considerarse para diagnosticar esta rara enfermedad. Convencionalmente, se practicaba un estudio radiológico del tránsito del intestino delgado, bajo observación fluoroscópica secuencial del paso del medio de contraste (bario). Sin embargo, este método presentaba muchas desventajas, como superposición de las asas que no permitían una buena visión, no detectar tumores pequeños, no evaluar la extensión de la enfermedad y depender del operador, por lo que su valor predictivo negativo era muy bajo 20.
Por esto, se utiliza más la tomografía computadorizada (TC), pues es muy sensible para detectar el tumor primario. Se observa generalmente como una lesión focal, irregular, estenosante, con engrosamiento mural, heterogénea, con realce en la fase contrastada y que, en ocasiones, puede disminuir la luz e incluso causar obstrucción intestinal; algunas veces se pueden observar lesiones ulceradas o polipoides. Además, la TC es útil para evaluar la extensión tumoral local y a distancia; las metástasis son más frecuentes en el hígado y se manifiestan como lesiones hipodensas con buen realce en la fase portal 21,22.
Por la dificultad de su diagnóstico, se han implementado nuevas técnicas en la actualidad, que han mejorado el hallazgo preoperatorio de estas lesiones, sin importar su localización y tamaño. Así sucede con la TC con enteróclisis, que consiste en una tomografía abdómino-pélvica con fase arterial y porto-venosa, en la cual se dilata el intestino con agua o solución contrastada mediante una sonda nasoentérica. Esto hace que la luz intestinal se vea hipodensa con paredes que captan el contraste, lo cual aumenta la sensibilidad hasta de 85 a 95 %, con una especificidad de 90 a 96 %, pudiéndose observar el tumor como una lesión anular estenosante de mínimo 3 mm de longitud 20,23.
Con respecto a las imagénes diagnósticas, han surgido otras herramientas, con tecnología más avanzada y mejores softwares de reconstrucción, como la TC multidetector con endoscoscopia virtual (Multi-Detector CT Virtual Endoscopy, MDCT-VE), la resonancia magnética con enteróclisis y la reconstrucción multiplano, entre otras 24.
La videocápsula es una herramienta innovadora, no invasiva, que permite evaluar el intestino por medio de una videocámara especial que ingiere el paciente y emite la señal a lo largo de su recorrido por el tubo digestivo. Esta técnica tiene sus limitaciones en pacientes con obstrucción intestinal o con tránsito rápido, y no permite tomar muestras histológicas; aunque se ha utilizado para tamización en pacientes con predisposición, no ha demostrado eficacia alguna 23.
La endoscopia flexible asistida por balón, con una sensibilidad de hasta 90 %, permite obtener imágenes de alta resolución y obtener muestras histológicas, por lo que podría considerarse el método diagnóstico de referencia 5,23,25.
La estadificación del cáncer de intestino delgado sigue los principios del sistema TNM (cuadro 1).
El único tratamiento curativo es la resección quirúrgica R0, usualmente con un margen de mínimo 5 cm, más la resección de los ganglios linfáticos locales y regionales. No se ha demostrado que la quimioterapia adyuvante mejore la supervivencia, aunque en ocasiones se ha visto reacción terapéutica con FOLFOX, además de irinotecan y gemcitabina, en la quimioterapia paliativa. Cuando hay lesiones adyacentes al tumor, se recomienda la resección en bloque y, si se considera irresecable, se recomienda la cirugía derivativa en casos de obstrucción intestinal, perforación o sangrado incontrolable 25,27,28. En el presente caso, el paciente se sometió a resección quirúrgica del tumor y los ganglios, con anastomosis de yeyuno.
Generalmente, el pronóstico en casos de tumores del intestino delgado es pobre, debido a que se diagnostican en etapas avanzadas. Los factores de mal pronóstico son, principalmente, infiltración de ganglios linfáticos, localización duodenal, tabaquismo, edad avanzada, pobre diferenciación y resecciones que no sean R0. La tasa de supervivencia a cinco años depende del estadio del tumor: en estadio I, es de 50 a 60 %; en estadio II, de 39 a 55 %; en estadio III, de 10 a 40 %, y en estadio IV, de 3 a 5 % 23,25,29.














